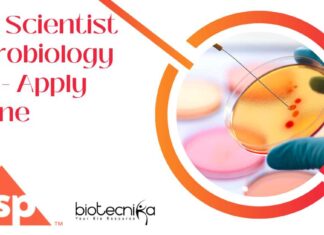
USP Scientist Microbiology Job – Apply Online USP Scientist Microbiology Job

BRIC-THSTI-JNU PhD Program Admission 2024-25 Winter Session, Apply Online
THSTI-JNU PhD 2024-25 Admissions - Applications Invited
Admission to the Ph.D. Program for the 2024-25 (Winter Session)
Applications are invited for the BRIC - THSTI...
Cancer Research Project Jobs at ACTREC! Apply Now for the Project...
Cancer Research Project Jobs at ACTREC! Apply Now for the Project Assistant Position!
TATA MEMORIAL CENTRE
ADVANCED CENTRE FOR TREATMENT, RESEARCH AND EDUCATION IN CANCER
Kharghar, Navi...
Hikal Executive Job Opening for MSc Microbiology – Apply Online
Hikal MSc Microbiology Job - Apply Online For Executive Job
Executive
Panoli, Gujarat, India
Job Identification: 1946
Job Category: Jr. Officer to Manager
Locations: Panoli
Posting Date: 12/27/2024, 01:00 PM
Apply...
Biotecnika Times Newsletter 27.12.2024 – Govt BIRAC Rs. 1.25 Lakh pm...
Govt BIRAC Vacancies With Rs. 1,25,000 pm Pay – Life & Biological Sciences Apply Online
Explore high-paying job opportunities at BIRAC and advance your career...
JNCASR Mol Bio & Biological Sciences Project Vacancy – Apply Now
JNCASR Mol Bio Project Job, Biological Sciences Apply Now
Advt.No. MML/04
Jawaharlal Nehru Centre For Advanced Scientific Research
Jakkur P.O., Bengaluru-560064, Karnataka, INDIA
An autonomous institution under Department...
Govt BIRAC Vacancies With Rs. 1,25,000 pm Pay – Life &...
BIRAC Job Openings For Life & Biological Sciences, Apply Online
Vacancy Ref. No: BIRAC/VAC/146/Dec-2024-CON
Biotechnology Industry Research Assistance Council (BIRAC) is a not-for-profit Section 8, Schedule B,...
USP Scientist Microbiology Job – Apply Online
USP Scientist Microbiology Job - Apply Online
Scientist II, Microbiology
Hyderabad, IND
Job Category: Publications
Job Type: Full-Time
Req ID: SCIEN002622
Description
Brief Job Overview:
The summary should be a brief, high-level...
Bioinformatics Project Vacancy at RCB – Apply Online
Bioinformatics Project Vacancy at RCB - Apply Online
Advt. No. 36/Project/2024/HR
Interview for “Project Associate-I” Position
Title of Project: “Bioinformatics Centre for Computational Drug Discovery- BIC at...
ILS BSc & MSc Life Sciences Project Vacancies – Apply Online
ILS Project Vacancies For Life Sciences - Apply Online
INSTITUTE OF LIFE SCIENCES
An organisation under the Biotechnology Research and Innovation Council (BRIC), Department of Biotechnology,...
Panacea Biotec QC Executive Job Opening – MSc Apply Online
Panacea Biotec QC Executive Job Opening - MSc Apply Online
Executive - QC Microbiology (EMP)
Baddi, Himachal Pradesh, India
About the job
Responsibilities:
To perform environmental monitoring (active...
Dr Reddy’s Biological Sciences Manufacturing Associate Job – Apply Online
Dr Reddy's Biological Sciences Manufacturing Associate Job - Apply Online
Manufacturing Associate (CAR-T)
Bengaluru, Karnataka, India
About the job
Company Description
Dr. Reddy’s Laboratories Ltd. is a leading multinational...
The Future of Gene Therapy: What’s Next for Biotech?
The Future of Gene Therapy: What’s Next for Biotech?
"We used to think that our fate was in our stars, but now we know that,...
Fortrea (Labcorp Company) Clinical Data Analyst Job – Apply Online
Fortrea Clinical Data Analyst Job - Life Sciences Apply Online
Sr Clinical Data Analyst
Locations: Bangalore
Time Type: Full time
Posted On: Posted Today
Job Requisition ID: 2447462
As a...
Biotecnika Times Newsletter 26.12.2024 – Novonesis Intern, HaystackAnalytics Paid Internship, Freshers...
Novonesis Intern For MSc, MTech Biotech & Microbiology, Apply Online
Novonesis msc, mtech biotech and microbiology internship
HaystackAnalytics Paid Internship For Bioinformatics, Apply Now
Apply for a...
Syngene MSc Biotech, Biochemistry Job Opening – Apply Online
Syngene MSc Biotech, Biochemistry Job Opening - Apply Online
Title: USP MSAT
Date: 26 Dec 2024
Job Location: Bangalore
JOB DESCRIPTION
Job Title: Senior Associate
Job Location: Bangalore, India
Level: 9
About...